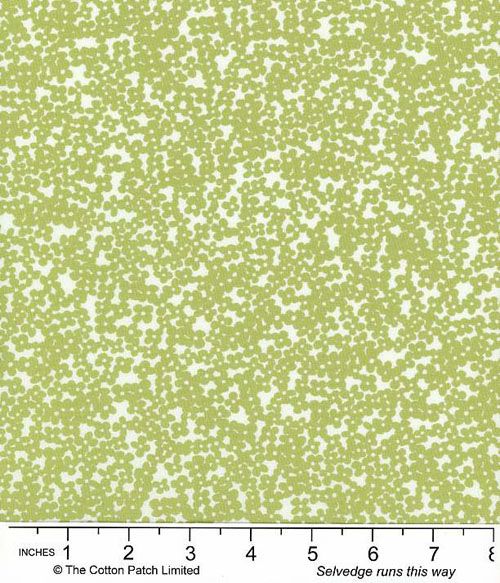
Juliette fabric, Tiny Floral, Light Green

The price shown for this Juliette fabric from Wilmington Prints is per quarter metre. Fabric can be purchased in quarter metre units.
For example, if you wish to order 1 ½ metres enter "6" as the quantity (6 x 1/4m = 1 ½ metres). The fabric will be sent as a single piece.
Fabric width is approximately 42" ‐ 44" (108 ‐ 112cm).
For example, if you wish to order 1 ½ metres enter "6" as the quantity (6 x 1/4m = 1 ½ metres). The fabric will be sent as a single piece.
Fabric width is approximately 42" ‐ 44" (108 ‐ 112cm).
Product Reviews
0 out of 5, based on 0 reviews
Verified Customer Reviews:
There are no reviews for this product yet.
Write a customer review
Tell us what you think of this product using the form below (please fill in all fields).
Please note your name may be published on this page and any other details stored in line with our privacy policy. Reviews are subject to verification before they are published.